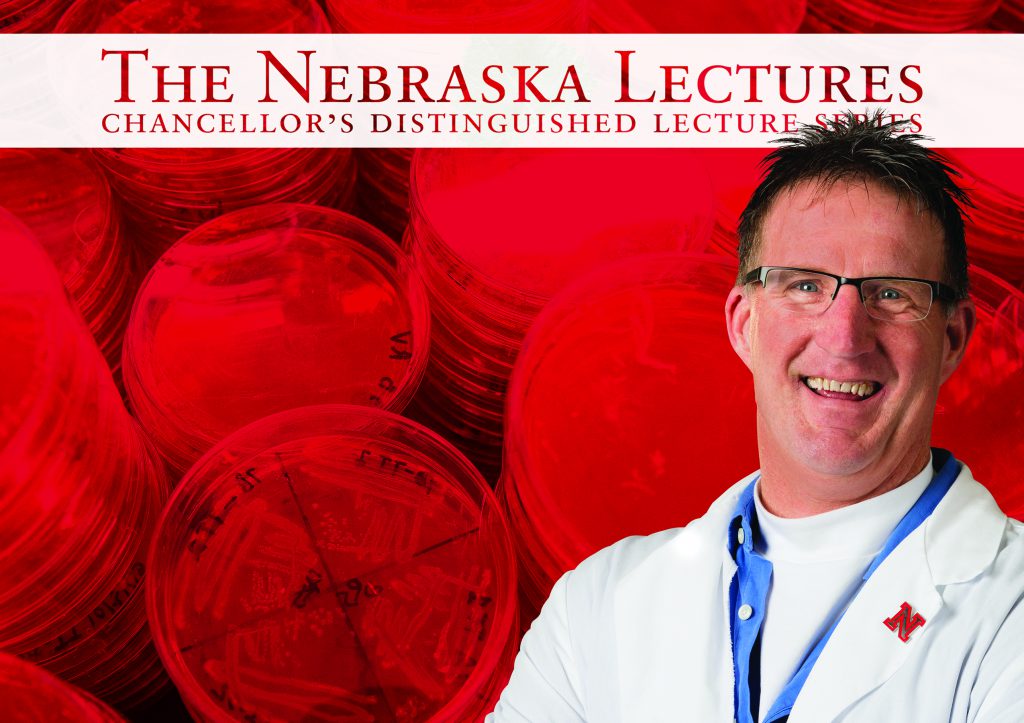

Research and Innovation
Research Development
Services and programs for research successSponsored Programs
Proposal submission and award managementResearch Responsibility
Research Compliance, Integrity, and SecurityInstitutional Animal Care Program
Research Safety